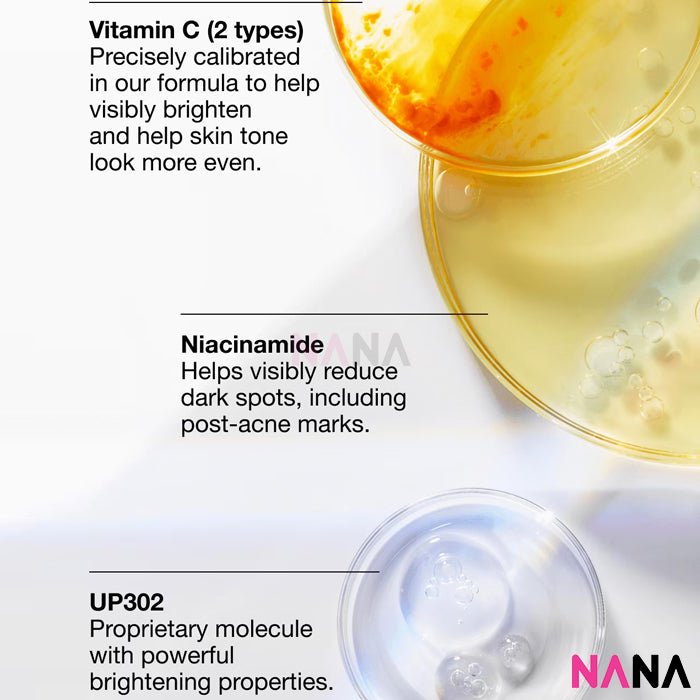
CLINIQUE Even Better Clinical Dark Spot Clearing Serum 100ml - NANA MALL

Benefits
Helps visibly reduce dark spots and PIH and improve brilliance.
Who It's For
All Skin Types
What It Is
Fourth generation brightening serum is a powerful dermatologist-developed solution for brilliant skin. The advanced formula, including our proprietary molecule UP302, balances more potent brightening actives with more soothing ones.*Clinically proven to fight six barriers to brighter-looking skin: dark spots, PIH, uneven tone, sallowness, dullness, and pores. Gentle enough for all skin types, including sensitive skin.
Dermatologist developed and tested. Safe for sensitive skin. Suitable for post-procedure skin.**Clinically tested on Asian skin. Allergy tested. 100% fragrance free.
*vs Even Better Clinical™ Radical Dark Spot Corrector + Interrupter.
**Shown to be safe for use beginning 1 day after Intense Pulsed Light (IPL) treatment in 2 week clinical usage test.
How To Use
- Use our serum for dark spots twice a day, morning and night. With regular use, see results on dark spots, PIH, and more.
- Dispense 1 to 2 pumps onto fingertips.
- Spread serum all over your face, avoiding eye area.
- Follow with moisturizer.
- Daily sunscreen is imperative. Apply in the AM after your moisturizer.